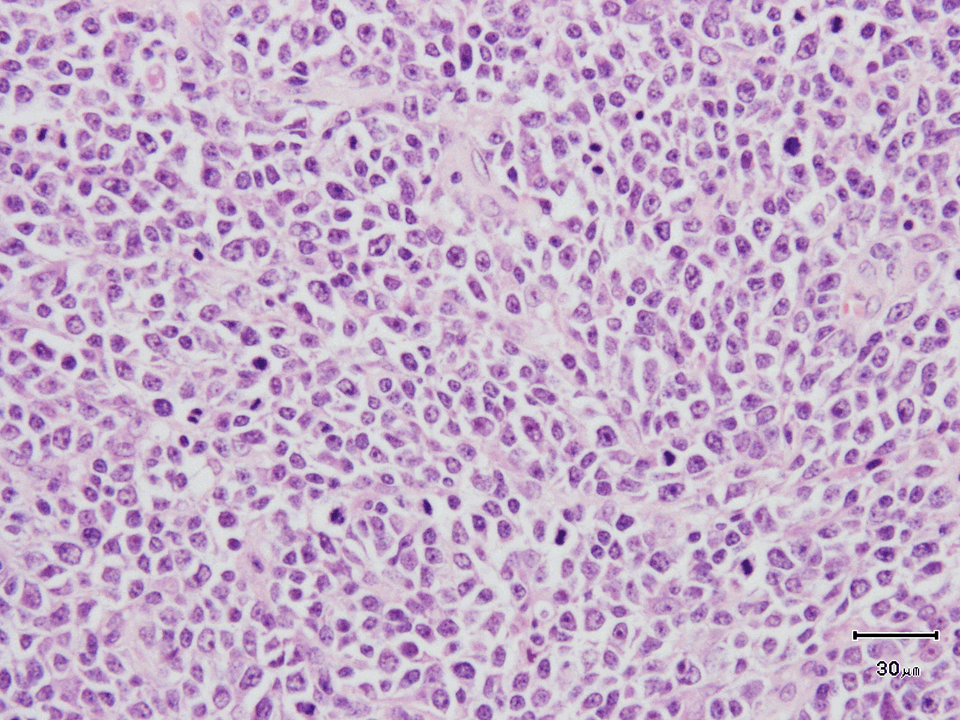
cover figure

Volume 1; Number 1 (September 2010) |
Cover Figure |
|
Microscopic appearance of the resected testis. Neoplastic infiltration by medium to large sized lymphoid cells with diffuse proliferation and without glandular structure. (Page 7) |
Go Back to Table of Contents |
|